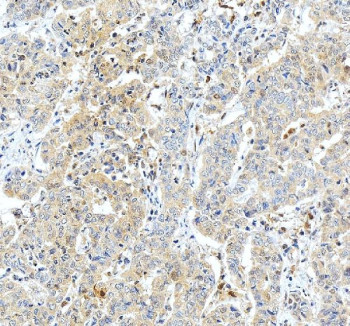
Anti-GSTO1 / Glutathione S-transferase omega 1

Cookie preferences
This website uses cookies, which are necessary for the technical operation of the website and are always set. Other cookies, which increase the comfort when using this website, are used for direct advertising or to facilitate interaction with other websites and social networks, are only set with your consent.
Configuration
Technically required
These cookies are necessary for the basic functions of the shop.
"Allow all cookies" cookie
"Decline all cookies" cookie
CSRF token
Cookie preferences
Currency change
Customer-specific caching
FACT-Finder tracking
Individual prices
Selected shop
Session
Comfort functions
These cookies are used to make the shopping experience even more appealing, for example for the recognition of the visitor.
Note
Show the facebook fanpage in the right blod sidebar
Statistics & Tracking
Affiliate program
Conversion and usertracking via Google Tag Manager
Track device being used
| Item number | Size | Datasheet | Manual | SDS | Delivery time | Quantity | Price |
|---|---|---|---|---|---|---|---|
| NSJ-FY12525 | 100 µg | - | - |
3 - 10 business days* |
790.00€
|
If you have any questions, please use our Contact Form.
You can also order by e-mail: info@biomol.com
Larger quantity required? Request bulk
You can also order by e-mail: info@biomol.com
Larger quantity required? Request bulk
Adding 0.2 ml of distilled water will yield a concentration of 500 ug/ml. GSTO1 antibody detects... more
Product information "Anti-GSTO1 / Glutathione S-transferase omega 1"
Adding 0.2 ml of distilled water will yield a concentration of 500 ug/ml. GSTO1 antibody detects Glutathione S-transferase omega-1, an enzyme belonging to the omega class of the glutathione transferase family. GSTO1 catalyzes reduction reactions and participates in antioxidant defense, detoxification, and redox homeostasis. Unlike classical GSTs, GSTO1 possesses dehydroascorbate reductase and deglutathionylase activities, enabling control of oxidative stress and protein thiol status. The GSTO1 antibody is widely used to study redox signaling, neurodegeneration, and inflammation.GSTO1 is encoded by the GSTO1 gene located on human chromosome 10q25.1. The protein is approximately 28 kilodaltons and features a cysteine residue in the active site instead of the usual serine or tyrosine found in other GSTs. This cysteine enables formation of mixed disulfides with substrates, granting GSTO1 unique catalytic and regulatory properties. The enzyme is mainly cytosolic but can associate with mitochondria and the endoplasmic reticulum during oxidative stress.The GSTO1 antibody identifies a 28 kilodalton band in western blot analysis and shows cytoplasmic distribution with enrichment in stress-responsive cells. GSTO1 reduces dehydroascorbate to ascorbic acid, maintaining vitamin C pools, and catalyzes deglutathionylation of oxidized proteins to restore function. It also contributes to mercury detoxification and participates in inflammatory signaling through modulation of interleukin-1beta processing.Variants in GSTO1 have been associated with altered susceptibility to Alzheimer's disease, Parkinson's disease, and certain cancers. By regulating redox balance and apoptosis, GSTO1 influences cellular survival and aging processes. Elevated expression is often observed in tumors and immune cells undergoing oxidative stress, whereas inhibition sensitizes cells to reactive oxygen species-induced death.GSTO1 is an important biomarker for antioxidant capacity and inflammatory regulation. Its enzymatic versatility links metabolism, detoxification, and immunity. NSJ Bioreagents provides a validated GSTO1 antibody optimized for its applications, supporting research into redox signaling, metabolic adaptation, and neuroinflammation.
| Keywords: | Anti-p28, Anti-Gsto1, Anti-Monomethylarsonic acid reductase, Anti-Glutathione S-transferase omega-1, Anti-S-(Phenacyl)glutathione reductase, Anti-Glutathione S-transferase omega 1-1, Anti-Glutathione-dependent dehydroascorbate reductase, GSTO1 Antibody / |
| Supplier: | NSJ Bioreagents |
| Supplier-Nr: | FY12525 |
Properties
| Application: | WB, IHC, FC, ELISA |
| Antibody Type: | Polyclonal |
| Conjugate: | No |
| Host: | Rabbit |
| Species reactivity: | mouse, rat |
| Immunogen: | E.coli-derived mouse GSTO1 recombinant protein (Position: E91-L240) |
| Format: | Purified |
Database Information
| KEGG ID : | K00799 | Matching products |
| UniProt ID : | O09131 | Matching products |
| Gene ID : | GeneID 14873 | Matching products |
Handling & Safety
| Storage: | +4°C |
| Shipping: | +4°C (International: +4°C) |
Caution
Our products are for laboratory research use only: Not for administration to humans!
Our products are for laboratory research use only: Not for administration to humans!
Information about the product reference will follow.
more
You will get a certificate here
Viewed